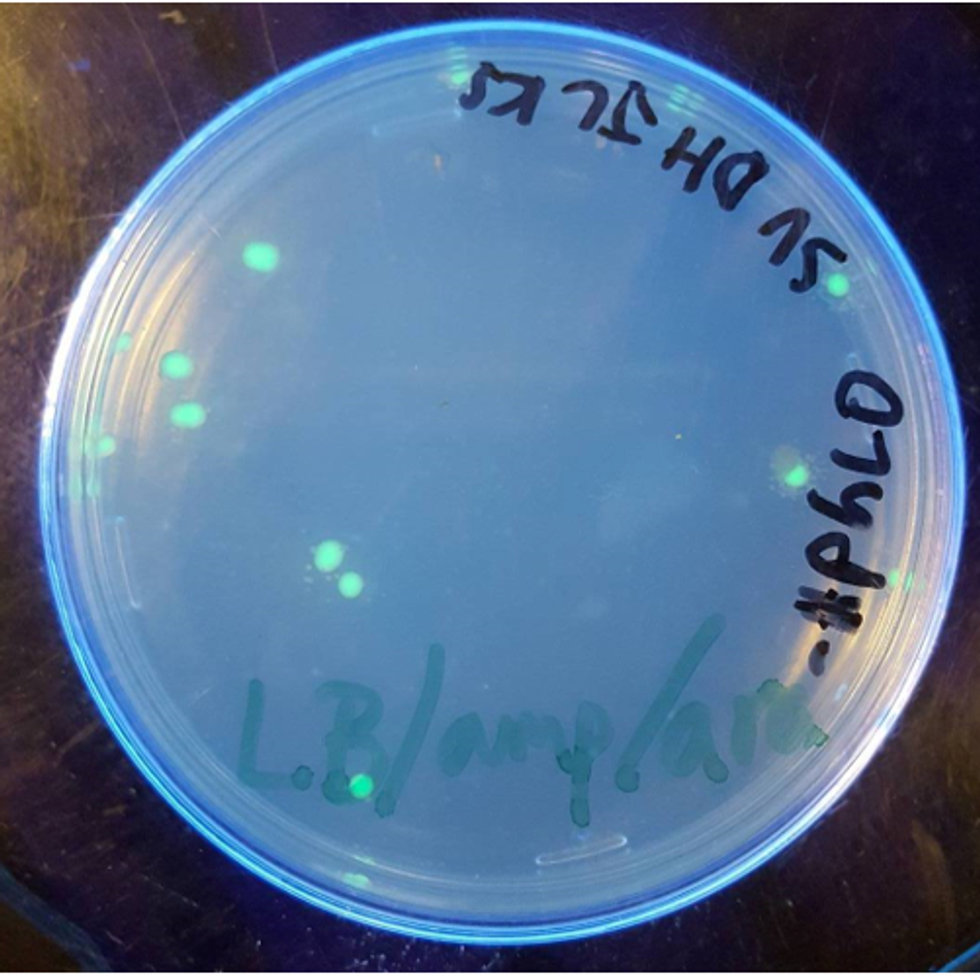
Bacteria

Transforming bacteria has been well documented in the Griffith experiment, and in a nutshell is when bacteria absorb external DNA and incorporate it into themselves to express genes. In Griffith's case, the R strain transformed into the S strain and killed the mouse when given S strain DNA.
In my 10th-grade molecular science class, I was given a lab to do after reading and discussing the Griffith experiment. My task was to use special pGLO plasmids (circular rings of DNA that bacteria can absorb) to transform E. coli so that they can express the genes for green fluorescent protein (GFP), which makes them glow green under ultraviolet light. We would then use those colonies of bacteria to obtain the purified protein.
The normal process of streaking the bacteria was the same as usual, but transforming bacteria wasn't very easy. Although we generously applied the plasmid suspension to the colonies, not all of the bacteria transformed. In fact, very few, if any, colonies transformed. This proved to be a bit of a problem because that meant we didn't have many colonies to work with. Furthermore, some of the colonies that didn't transform were competing with the ones that did transform for nutrients, and given that we were dealing with a culture with limited nutrients, the growth of the transformed bacterial colonies would be stunted.
Luckily, we learned that those plasmids also contained antibiotic resistance genes, specifically to ampicillin. We were able to use ampicillin to select for the transformed bacteria, as the ampicillin would be harmless to the latter but kill all of the original ones. Therefore, we drastically reduced competition and thus could grow more colonies as well as larger ones.
The best part of this lab was that we learned how to use column chromatography to purify the GFP from the bacterial suspension. We had to kill the bacteria and use various detergents to isolate the protein. It was quite frustrating at first, given that the column worked incredibly slowly and we had limited time in the class, but we managed to finish purifying the protein over the next week. We got incredible results when we shined a black light on a pure suspension of the protein, which looked like this:

Getting that green beam confirmed that our purification was a success, and I was ecstatic. I learned so much from that one lab, such as selecting for the proper bacteria to be used in the experiment as well as column chromatography. I'm quite thankful that I was able to transform bacteria, the results really do shine!